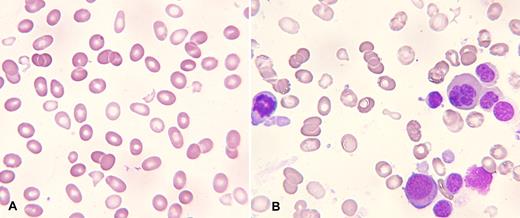
A 67-year-old man with polycythemia vera on hydroxyurea for 4 years presented with an abrupt pancytopenia requiring admission and transfusion support. His CBC revealed WBC 2.3 × 109/L, neutrophils 1.2 × 109/L, hemoglobin 62 g/L, MCV 94 fL, and platelets 16 × 109/L. The reticulocyte count was < 1 × 109/L, LDH and bilirubin were slightly elevated, and coagulation tests were normal. / On the peripheral blood film, there was a moderate degree of red cell fragmentation (panel A) with ovalocytes, teardrop cells, and a near absence of neutrophils and platelets. A bone marrow aspirate (panel B) and biopsy were obtained. The incidence of myeloblasts was < 5% by both morphologic and flow cytometric evaluation. Morphologic examination of the aspirate demonstrated marked dyserythropoiesis with red cell fragments in the background (panel B). Bone marrow cytogenetic karyotyping revealed deletions in 5q, 7q, and 20q. A diagnosis of myelodysplastic syndrome, refractory cytopenia with multilineage dysplasia (RCMD), was made with intermediate-2 score on the International Prognostic Scoring System (IPSS). / This case illustrates the development of myelodysplastic syndrome from previous polycythemia vera that was detected by marked pancytopenia and peripheral blood smear abnormalities that included red cell fragmentation.

A 67-year-old man with polycythemia vera on hydroxyurea for 4 years presented with an abrupt pancytopenia requiring admission and transfusion support. His CBC revealed WBC 2.3 × 109/L, neutrophils 1.2 × 109/L, hemoglobin 62 g/L, MCV 94 fL, and platelets 16 × 109/L. The reticulocyte count was < 1 × 109/L, LDH and bilirubin were slightly elevated, and coagulation tests were normal.
On the peripheral blood film, there was a moderate degree of red cell fragmentation (panel A) with ovalocytes, teardrop cells, and a near absence of neutrophils and platelets. A bone marrow aspirate (panel B) and biopsy were obtained. The incidence of myeloblasts was < 5% by both morphologic and flow cytometric evaluation. Morphologic examination of the aspirate demonstrated marked dyserythropoiesis with red cell fragments in the background (panel B). Bone marrow cytogenetic karyotyping revealed deletions in 5q, 7q, and 20q. A diagnosis of myelodysplastic syndrome, refractory cytopenia with multilineage dysplasia (RCMD), was made with intermediate-2 score on the International Prognostic Scoring System (IPSS).
This case illustrates the development of myelodysplastic syndrome from previous polycythemia vera that was detected by marked pancytopenia and peripheral blood smear abnormalities that included red cell fragmentation.
A 67-year-old man with polycythemia vera on hydroxyurea for 4 years presented with an abrupt pancytopenia requiring admission and transfusion support. His CBC revealed WBC 2.3 × 109/L, neutrophils 1.2 × 109/L, hemoglobin 62 g/L, MCV 94 fL, and platelets 16 × 109/L. The reticulocyte count was < 1 × 109/L, LDH and bilirubin were slightly elevated, and coagulation tests were normal.
On the peripheral blood film, there was a moderate degree of red cell fragmentation (panel A) with ovalocytes, teardrop cells, and a near absence of neutrophils and platelets. A bone marrow aspirate (panel B) and biopsy were obtained. The incidence of myeloblasts was < 5% by both morphologic and flow cytometric evaluation. Morphologic examination of the aspirate demonstrated marked dyserythropoiesis with red cell fragments in the background (panel B). Bone marrow cytogenetic karyotyping revealed deletions in 5q, 7q, and 20q. A diagnosis of myelodysplastic syndrome, refractory cytopenia with multilineage dysplasia (RCMD), was made with intermediate-2 score on the International Prognostic Scoring System (IPSS).
This case illustrates the development of myelodysplastic syndrome from previous polycythemia vera that was detected by marked pancytopenia and peripheral blood smear abnormalities that included red cell fragmentation.
Many Blood Work images are provided by the ASH IMAGE BANK, a reference and teaching tool that is continually updated with new atlas images and images of case studies. For more information or to contribute to the Image Bank, visit http://imagebank.hematology.org.

This feature is available to Subscribers Only
Sign In or Create an Account Close Modal